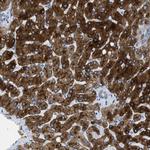
ASGR1 Antibody in Immunohistochemistry (IHC)

Search
Invitrogen
ASGR1 Polyclonal Antibody
{{$productOrderCtrl.translations['antibody.pdp.commerceCard.promotion.promotions']}}
{{$productOrderCtrl.translations['antibody.pdp.commerceCard.promotion.viewpromo']}}
{{$productOrderCtrl.translations['antibody.pdp.commerceCard.promotion.promocode']}}: {{promo.promoCode}} {{promo.promoTitle}} {{promo.promoDescription}}. {{$productOrderCtrl.translations['antibody.pdp.commerceCard.promotion.learnmore']}}
产品信息
PA5-52885
种属反应
宿主/亚型
分类
类型
抗原
偶联物
形式
浓度
规格
纯化类型
保存液
内含物
保存条件
运输条件
RRID
产品详细信息
Immunogen sequence: MTKEYQDLQH LDNEESDHHQ LRKGPPPPQP LLQRLCSGPR L
Highest antigen sequence identity to the following orthologs: Mouse - 76%, Rat - 76%.
靶标信息
The asialoglycooprotein receptor (ASGPR) is a transmembrane glycoprotein (42 kDa) which mediates binding, internalization and degradation of extracellular glycoproteins that have exposed terminal galactose residues. The receptor is expressed on the surface of the hepatocytes in a polar manner, i. e. it is present on the sinusoidal and lateral plasma membranes but not on the bile canalicular membrane. The mammalian hepatic ASGPR mediate the endocytosis and degradation of serum proteins from which terminal sialic residues have been removed. The rat asialoglycoprotein receptor (ASGPR) consists of three polypeptide subunits: rat hepatic lectin (RHL)-1, RHL-2 and RHL-3. The monoclonal antibody 8D7 recognizes a subunit-specific epitope of RHL-1 of rat ASGPR. The monoclonal antibody 8D7 is cross reactive with human ASGPR.
仅用于科研。不用于诊断过程。未经明确授权不得转售。
篇参考文献 (0)
生物信息学
蛋白别名: ASGP-R 1; ASGR1; Asialoglycoprotein receptor 1; asialoglycoprotein receptor 1b; asialoglycoprotein receptor H1; C-type lectin domain family 4 member H1; Hepatic lectin H1; HL-1
基因别名: ASGPR; ASGPR1; ASGR1; CLEC4H1; HL-1
UniProt ID: (Human) P07306
Entrez Gene ID: (Human) 432